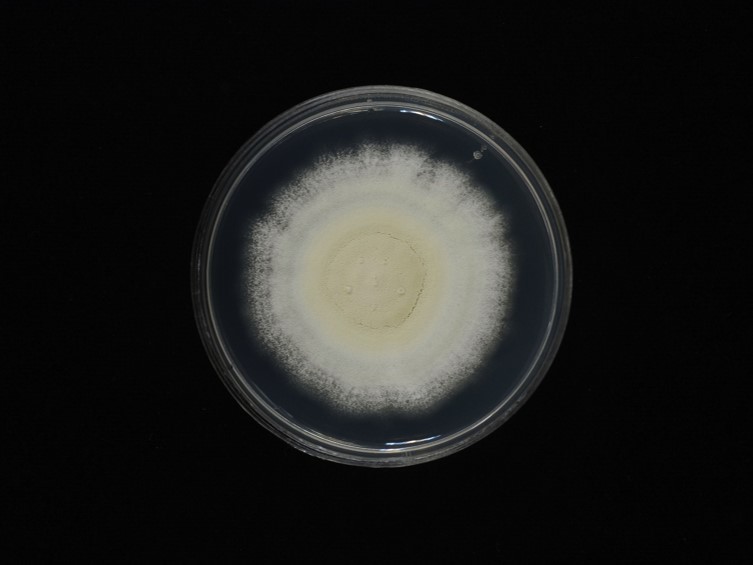

Holotype:
THAILAND, Nakhon Ratchasima Province, Khao Yai National Park, 20 May 1996, K. Tasanathai, N.L. Hywel-Jones, S. Sivichai, S. Thienhirun, holotype BBH 5054, ex-type living culture BCC 1848.
Habitat:
Leaf litters.
Host:
Adult beetles, weevils, adult cicada, ants, larvae and adult of moth.
Description:
 Hosts covered with white mycelium, powdery while sporulating.
Hosts covered with white mycelium, powdery while sporulating.  Phialides hyaline, solitary, smooth-walled, base ovoid, subspherical, 2-3.5 × 2-3 μm.
Phialides hyaline, solitary, smooth-walled, base ovoid, subspherical, 2-3.5 × 2-3 μm.  Conidia hyaline, smooth-walled, globose, occasionally subglobose, 2-3 × 1.5-2.5 μm.
Conidia hyaline, smooth-walled, globose, occasionally subglobose, 2-3 × 1.5-2.5 μm.
Culture characteristics:
Colony on PDA growth at room temperature attaining a diam of 20−21 mm in 10 d, 40−41 mm in 20 d, surface mycelium dense, floccose, sporulation starts 5 d after inoculation, white with green-yellow, powdery when sporulating.
Colony on PDA growth at room temperature attaining a diam of 20−21 mm in 10 d, 40−41 mm in 20 d, surface mycelium dense, floccose, sporulation starts 5 d after inoculation, white with green-yellow, powdery when sporulating.
Reference:
Kobmoo N, Arnamnart N, Pootakham W, et al. (2021). The integrative taxonomy of Beauveria asiatica and B. bassiana species complexes with whole-genome sequencing, morphometric and chemical analyses. Persoonia 47: 136–150.
DOI: https://doi.org/10.3767/persoonia.2021.47.04Species |
Strain |
Compound |
Pubchem CID |
Biological activity |
Reference |
|---|
|
Strain |
Bloc | ITS | RPB1 | RPB2 | TEF1 |
|---|---|---|---|---|---|
| BCC 1446 | MN401541 | MN401671 | MN401596 | MN401619 | MN401499 |
| BCC 1848 | MN401540 | MN401670 | MN401595 | MN401618 | MN401498 |
| BCC 2660 | - | MN401675 | MN401620 | MN401503 |